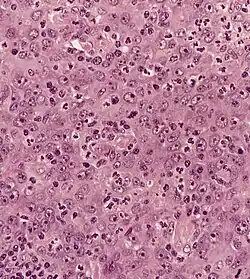
Ilustracja

Rak jamy nosowo-gardłowej
| carcinoma nasopharyngis carcinoma cavi nasopharyngis | |
![]() Obraz histologiczny przerzutu raka nosogardła do węzła chłonnego, barwienie H-E | |
| Klasyfikacje | |
| ICD-10 |
C11 |
|---|---|
| DiseasesDB | |
| OMIM | |
| MeSH | |


Rak jamy nosowo-gardłowej, rak nosogardła, rak nosogardzieli (łac. carcinoma nasopharyngis, carcinoma cavum nasopharyngis, ang. nasopharyngeal carcinoma) – rzadki nowotwór złośliwy (rak) lokalizujący się w nosowej części gardła (nasopharynx). Zaliczany do grupy nowotworów głowy i szyi.
Historia
Pierwszy dostępny opis tego nowotworu na podstawie grupy 14 chorych podał na łamach JAMY w 1901 roku Jackson[2]. Jeden z typów raka części nosowej gardła – nabłoniak limfatyczny (łac. lymphoepithelioma) został wydzielony niezależnie przez francuskiego radiologa Claude’a Regauda (1870-1941)[3] i niemieckiego patologa Alexandra Schminckego (1877-1953)[4] w 1921 roku; stąd historyczna nazwa tego typu raka: guz Schminckego-Regauda[5]. Dalsze szczegółowe badania nad biologią i histopatologią tego nowotworu prowadził Kenelm H. Digby[6][7]. Przełomowym etapem dla poznania biologii tego nowotworu okazało się wykrycie w 1976 związku pomiędzy rozwojem raka części nosowej gardła a zakażeniem wirusem EBV (patrz niżej). W pracy traktującej o tej korelacji Henle donosił o wysokim poziomie przeciwciał klasy IgA przeciwko wirusowi EBV u chorych z rakiem nosogardła[8].
Epidemiologia
Rak nosogardła jest stosunkowo rzadko występującym nowotworem. W Polsce stwierdza się około 150 nowych przypadków rocznie[9]. Obserwuje się dwa szczyty zachorowań: między 15. a 25. rokiem życia oraz po 45. roku życia. Roczna zapadalność w Wielkiej Brytanii na raka nosogardła wynosi 0,3:1 000 000 w przedziale wiekowym 0-14 lat i 1-2:1 000 000 w przedziale 15-19 lat[10]. W krajach europejskich zapadalność na ten nowotwór jest niska. W niektórych rejonach świata nowotwór ten występuje endemicznie. Najczęstsze zachorowania notuje się w południowo-wschodniej Azji, głównie w południowych regionach Chin, gdzie zapadalność roczna wynosi 20:100 000[11]. W tych krajach nowotwór znajduje się w czołówce zapadalności na nowotwory złośliwe. Wysoki odsetek zachorowań na raka części nosowej gardła obserwuje się także na Alasce i w południowej części basenu Morza Śródziemnego np. w Tunezji[12]. Szczególnie predysponowani do zachorowania na raka części nosowej gardła są rdzenni mieszkańcy chińskiej prowincji Guangdong oraz Inuici[13]. Endemia w przypadku raka nosogardła ma podłoże genetyczne, a także może mieć związek z czynnikiem rasowym oraz środowiskowym. Dowodem na to jest fakt, że zachorowalność na raka części nosowej gardła jest nadal wysoka wśród Chińczyków, którzy przyjeżdżają i osiedlają się w regionach południowo-wschodniej Azji a pozostaje niska wśród chińskiej społeczności, zamieszkującej na przykład w Ameryce Północnej[14].
Etiologia
W etiologii raka nosogardła udowodniono rolę następujących czynników:
- zakażenia wirusem Epsteina-Barr (EBV)[15] – głównie w przypadku raków nierogowaciejących (dawniej typy II i III[16]) patrz niżej.
- spożywanie ryb konserwowanych solą (solone ryby stanowią m.in. element kuchni kantońskiej) i zawierających przez to rakotwórcze nitrozoaminy[17][18][19].
Proponowano także udział następujących czynników:
- niedoboru witaminy C (w typie I raka nosogardła)[20].
- czynników genetycznych, m.in. polimorfizmów genu TLR3 kodującego receptor odgrywający rolę w infekcji komórek wirusem EBV; w jednej pracy wykazano, że polimorfizm
829A/Cznacząco zwiększał ryzyko raka nosogardła w kantońskiej populacji (p=0,0068, OR=1,49, 95%CI:1,10–2,00)[21].
Anatomia kliniczna
Najczęściej punktem wyjścia raka jest boczna ściana jamy nosowo-gardłowej: zachyłek Rosenmüllera, szczelinowata przestrzeń położona tuż za ujściem gardłowym trąbki słuchowej lub też sama okolica jej ujścia. Może on rozwijać się także na górnej ścianie części nosowej gardła czyli na stopie gardła. Guz rozwija się najczęściej rosnąc w głąb podłoża (endofitycznie) rzadko przybierając postać kalafiorowatą (egzofityczną). Rośnie on także często pod niezmienioną błoną śluzową. Z tego powodu bardzo szybko dochodzi do naciekania mięśni podniebienia, a szczególnie mięśnia dźwigacza podniebienia miękkiego. Rak części nosowej gardła charakteryzuje się dużą złośliwością miejscową. Wynika ona między innymi z „krytycznego” położenia części nosowej gardła: punktem wyjścia zwykle jest szczelinowata przestrzeń na ścianie bocznej, początkowo „niema klinicznie”: nie dająca objawów i trudno dostępna badaniu laryngologicznemu. Ku górze od części nosowej gardła znajduje się podstawa czaszki, a w niej liczne otwory i szczeliny zawierające nerwy czaszkowe, które ułatwiają ekspansję nowotworu na sąsiadujące tkanki. Dokładnie w rzucie przyczepu bocznej ściany gardła do podstawy czaszki znajduje się otwór poszarpany a nieco do boku od niego otwór owalny. Zajęcie przez szerzący się naciek nowotworowy wymienionych otworów wraz z ich zawartością daje charakterystyczne zespoły objawów neurologicznych (patrz niżej). Brak barier anatomicznych ułatwia także rozprzestrzenianie się raka nosogardła ku dołowi w kierunku podniebienia. Powierzchowna ekspansja raka do boku powoduje łatwe zajęcie trąbki słuchowej z jej zatkaniem i dalszymi następstwami klinicznymi. Ku tyłowi i także do boku naciek guza jest częściowo spowolniony przez barierę anatomiczną jaką stanowi powięź gardłowo-podstawna. Jednak znajduje się w niej miejsce, przez które rak może się łatwo rozprzestrzeniać. Jest to zatoka Morgagniego. Po jej przekroczeniu rak powoduje zajęcie głębokich przestrzeni trzewnych w okolicy podstawy czaszki (górna część przestrzeni przygardłowej) i wczesne przerzuty do węzłów chłonnych przestrzeni zagardłowej, a później do węzłów chłonnych głębokich szyi. Rak części nosowej gardła posiada także zdolność do niszczenia kości (osteolizy), co ułatwia mu przechodzenie do sąsiadujących okolic anatomicznych. W takich przypadkach najczęściej dochodzi do zniszczenia stoku i ekspansję do jamy czaszki z naciekaniem opony twardej. Rak jamy nosowo-gardłowej rozprzestrzenia się ku przodowi w kierunku nozdrzy tylnych i jamy nosowej. Z powodu endofitycznego charakteru wzrostu guza „zatkanie” (obturacja) jamy nosowej w przypadku guza rosnącego podśluzówkowo jest możliwa po długim czasie wzrostu. Dużo częściej w tej okolicy rak nosogardła szerzy się do boku i przez otwór klinowo-podniebienny wnika do dołu skrzydłowo-podniebiennego a stamtąd przez szczelinę oczodołową dolną szerzy się do szczytu oczodołu a do boku osiąga dół podskroniowy. Dalej ku przodowi w kierunku bocznym na wysokości jamy nosowej może on wchodzić do błędnika sitowego oraz także do oczodołu.
Klasyfikacja histopatologiczna
Według starego podziału histologicznego raka nosogardła WHO wyróżniała trzy typy tego guza[22]:
- typ I: dobrze zróżnicowany, rogowaciejący rak płaskonabłonkowy, który odpowiada typowemu rakowi płaskonabłonkowemu górnego odcinka drogi oddechowo-pokarmowej
- typ II: słabo zróżnicowanym nierogowaciejący rak płaskonabłonkowy
- typ III: nabłoniak chłonny (lymphoepithelioma) zwany guzem Schminckiego. Nazwa guza pochodzi od utkania i obecności komórek budujących tkankę limfatyczną oraz nabłonkową. Jak sądzono guz ten rozwija się z tkanki nabłonkowej pokrywającej elementy chłonne części nosowej gardła (migdałek gardłowy lub migdałek trąbkowy).
Obecna klasyfikacja raków części nosowej gardła pochodzi z 1991 roku. Wyróżnia ona następujące typy guzów[23]:
- rak płaskonabłonkowy rogowaciejący (ang. keratinising squamous-cell carcinoma) – jest to I typ według starej klasyfikacji WHO. Komórki guza charakteryzują się dobrym zróżnicowaniem z występowaniem rogowacenia
- rak nierogowaciejący (ang. non-keratinising carcinoma) – typ ten zawiera dodatkowo dwa podtypy odpowiadające dawniejszym II i III według starej klasyfikacji WHO. Zgrupowanie obu podtypów wynika z podobnej biologii tych nowotworów, dużej promieniowrażliwości (większej niż typ I) oraz większej korelacji z nadkażeniem wirusem EBV. Wśród raków nierogowaciejących wyróżniamy:
- zróżnicowany rak nierogowaciejący (ang. differentiated non-keratinising carcinoma) – dawny typ II. Komórki raka wykazują cechy różnicowania i dojrzałości, jednakże cechy świadczące o ich zróżnicowaniu w kierunku raka płaskonabłonkowego nie są widoczne w mikroskopii świetlnej.
- rak niezróżnicowany (ang. undifferentiated carcinoma) – to dawny nabłoniak limfatyczny (guz Schminckiego lub rak przejściowokomórkowy). Komórki w tym typie raka mają okrągłe lub owalne pęcherzykowate jądro z dobrze widocznym jąderkiem. Granice międzykomórkowe są niewyraźne, a komórki są bezładnie porozrzucane, nie tworząc warstw.
Objawy i przebieg
Rak części nosowej gardła w początkowym okresie rozwija się w sposób skryty, nie dając żadnych objawów klinicznych. Następnie wczesne fazy wzrostu guza dają niecharakterystyczne objawy. Przeciętnie okres, jaki upływa pomiędzy pojawieniem się pierwszych objawów klinicznych a postawieniem ostatecznego rozpoznania choroby nowotworowej, wynosi 8-10 miesięcy[24].
- u większości chorych pierwszym objawem klinicznym są przerzuty do węzłów chłonnych szyi, które manifestują się jako limfadenopatia szyjna
- pacjenci często są początkowo leczeni przez neurologów z powodu zajęcia nerwów czaszkowych (najczęściej n.III, n.V, n.VI i n.XII)[25]
- początkowo także niecharakterystycznym objawem jest przewlekły nieżyt nosa i zatok przynosowych
Wczesne objawy wzrostu guza na bocznej ścianie gardła grupują się w charakterystyczną triadę objawów zwaną zespołem Trottera:
- obturacja i naciek trąbki słuchowej przyczynia się do wysiękowego zapalenia ucha środkowego; każdy dorosły pacjent z jednostronnym wysiękowym zapaleniem lub nawracającym zapaleniem ucha środkowego wymaga starannej oceny nosogardła przez otorynolaryngologa
- otalgia
- niespecyficzne bóle głowy, o różnym nasileniu i lokalizacji, spowodowane naciekiem podstawy czaszki przez nowotwór
- objawy zajęcia zatoki jamistej z naciekiem nerwów czaszkowych oraz ściany tętnicy szyjnej wewnętrznej, które powoduje powstanie przerzutów odległych
- uszkodzenia nerwów czaszkowych, spowodowane naciekiem podstawy czaszki i jej otworów; zwykle grupują się one w charakterystyczne zespoły kliniczne:
- zespół Negri-Jacod, czyli zespół skalisto-klinowy
- zespół Villareta, czyli zespół przestrzeni zaprzyuszniczej
- zespół Tapii
- obturacja nozdrzy tylnych i krwawienie z nosa jest zwykle rzadkim objawem
- cuchnienie z ust i nosa spowodowane martwiczym rozpadem mas guza (późny objaw)
W analizie jak dotąd największej grupy chorych (4768) częstość występowania poszczególnych objawów przedstawia się następująco[26]:
- guz na szyi 76%
- przewlekły nieżyt nosa 73%
- objawy uszne 62%
- bóle głowy 35%
- dwojenie (diplopia) 11%
- drętwienie na twarzy 8%
- utrata wagi 7%
- szczękościsk 3%.
Wśród tej grupy chorych porażenia nerwów czaszkowych występowały w 20%.
Przerzuty raka części nosowej gardła
Przerzuty w raku nosogardła są zjawiskiem bardzo częstym. Miejscowe i lokoregionalne dotyczą najczęściej węzłów chłonnych. Jako pierwsze zajęte są węzły chłonne przestrzeni zagardłowej a w dalszej kolejności węzły chłonne leżące w przestrzeni przygardłowej. Węzły chłonne zagardłowe zajęte są zwykle w 65%[27]. Stamtąd przerzuty przedostają się drogą naczyń chłonnych do węzłów głębokich szyi. Należy zaznaczyć, że występowanie przerzutów do węzłów chłonnych szyi nie koreluje z zaawansowaniem miejscowym nowotworu. Innymi słowy: wyczuwalne i dostępne badaniu przerzuty węzłowe na szyi mogą pojawić się nawet w przypadku braku widocznego w badaniu rynoskopowym guza w nosogardle co często może być interpretowane jako przerzut z nieznanego ogniska pierwotnego. Złym rokowniczo objawem jest występowanie przerzutów węzłowych w dolnej części szyi (dół nadobojczykowy), gdyż u tych chorych występują najczęściej także przerzuty odległe. Występowanie przerzutów odległych przedstawia się następująco[28]:
Najczęściej stosowaną klasyfikacją zaawansowania raków części nosowej gardła jest klasyfikacja TNM według AJCC z 2002 roku[29]. Największe zarzuty dotyczące przydatności klinicznej podziału TNM, odnoszą się do nieuwzględniania przerzutów do zagardłowych węzłów chłonnych, których obecność jest czynnikiem skrajnie niekorzystnym. System TNM nie uwzględnia również głębokości naciekania nowotworu, stanu ogólnego chorych oraz różnych typów histologicznych, a co za tym idzie odmiennej biologii guzów nosogardła. Nadal stosowana jest klasyfikacja przerzutów do węzłów chłonnych szyi opracowana w 1978 roku przez Ho[30], według której szyja zostaje podzielona na część dolną i górną przez linię biegnącą od mostkowego końca obojczyka do górnego przyczepu mięśnia czworobocznego po stronie przeciwnej. Przerzuty w części dolnej rokują gorzej. Ho uważa, że obustronne przerzuty również pogarszają rokowanie.
| Stadium | Opis |
| Tx | Brak możliwości oceny guza pierwotnego |
| T0 | Brak cech guza pierwotnego |
| TIS | Rak in situ |
| T1 | Guz ograniczony do części nosowej gardła |
| T2 | Guz przechodzi do tkanek miękkich części ustnej gardła i (lub) jam nosa |
| T2a | Guz nie szerzy się do tkanek przestrzeni przygardłowej |
| T2b | Guz szerzy się do tkanek przestrzeni przygardłowej, naciekając do tyłu lub do boku poza powięź gardłowo-podstawną |
| T3 | Guz nacieka struktury kostne i (lub) zatoki przynosowe |
| T4 | Guz szerzy się do wnętrza czaszki i (lub) nacieka nerwy czaszkowe, dół podskroniowy, część krtaniową gardła, oczodół, przestrzeń mięśnia żwacza i mięśni skrzydłowych |
| Nx | Brak możliwości oceny przerzutów węzłowych w regionalnych węzłach chłonnych |
| N0 | Brak przerzutów do regionalnych węzłów chłonnych |
| N1 | Jednostronny przerzut lub przerzuty do węzłów chłonnych powyżej dołu nadobojczykowego, do 6 cm w największym wymiarze |
| N2 | Obustronne przerzuty do węzłów powyżej dołu nadobojczykowego, do 6 cm w największym wymiarze |
| N3a | Przerzuty jedno lub obustronne do węzła/węzłów powyżej dołu nadobojczykowego, powyżej 6 cm w największym wymiarze |
| N3b | Przerzuty jedno- lub obustronne do węzła/węzłów w dole nadobojczykowym |
| Mx | Brak możliwości oceny przerzutów odległych |
| M0 | Brak przerzutów odległych |
| M1 | Stwierdzone przerzuty odległe |
Rozpoznanie
Rozpoznanie raka nosogardła, zwłaszcza we wczesnym okresie choroby, określane jest jako trudne[31]. Wynika ono ze skąpych i niecharakterystycznych objawów w początkowym okresie rozwoju choroby. Opiera się ono na:
- badaniu ORL
- badanie otoskopowe i ocena błon bębenkowych; u chorych z rakiem jamy nosowo-gardłowej zwykle widoczne jest wciągnięcie błony w przypadku nieżytu trąbkowego lub poziom płynu w jamie bębenkowej w przypadku wysiękowego zapalenia ucha
- badaniu przedmiotowym części nosowej gardła, oglądaniem (w rynoskopii tylnej i w endoskopii) – nazofaryngoskopia
- badanie palpacyjne jamy nosowo-gardłowej zwykle ma wątpliwą wartość kliniczną. Jego założenie opierało się na możliwości rozpoznania nowotworu szerzącego się podśluzówkowo (endofitycznie).
- w badaniu jamy ustnej i gardła należy zwrócić uwagę na możliwość ubytków neurologicznych związanych z zajęciem odpowiednich nerwów czaszkowych (zaburzenie ruchomości języka, asymetria podniebienia itp). Ważne jest też badanie fiberoskopowe części ustnej gardła i oceny ewentualnego zajęcia struktur gardła środkowego
- każdorazowo otolaryngolog musi zbadać palpacyjnie węzły chłonne szyi, gdyż przerzuty do układu chłonnego szyi występują bardzo często, a także nierzadko stanowią pierwszy objaw kliniczny choroby.
- ocenie histopatologicznej wycinków guza – która determinuje postępowanie lecznicze, gdyż różne typy raka nosogardła charakteryzują się odmiennymi cechami klinicznymi. Wycinki uzyskuje się podczas endoskopowego badania części nosowej gardła przez otolaryngologa; rzadko wykonuje się bac podejrzanego o przerzut węzła chłonnego szyi
- badania obrazowe:
- CT – jest metodą z wyboru. Daje możliwość oceny ekspansji guza pierwotnego. Dzięki tomografii komputerowej możliwa jest też dokładna ocena zajęcia kości. Dodatkowo bardziej szczegółową metodą zwłaszcza w ocenie zajęcia przez nowotwór podstawy czaszki daje opcja HR CT – tomografia komputerowa wysokiej rozdzielczości(ang. high resolution computed tomography)
- MRI uznawana jest za metodę bardziej czułą. Dzięki niej możliwa jest ocena szerzenia się nowotworu wzdłuż otoczek nerwowych i wewnątrzczaszkowo oraz zajęcie węzłów chłonnych przestrzeni zagardłowej, która nie jest dostępna badaniu przedmiotowemu
- USG wykonuje się celem oceny układu chłonnego szyi pod kątem obecności przerzutów. Ważna jest ocena przepływu krwi w tętnicach szyjnych, gdyż naciek ściany tętnicy powoduje, że chory nie może być leczony operacyjnie. Alternatywą jest wtedy napromienianie układu chłonnego szyi
- PET – jest dobrą ale słabo dostępną w Polsce metodą diagnostyczną. Z tego powodu może ona służyć do oceny przerzutów odległych raka części nosowej gardła
Ze względu na dużą tendencję guza do rozsiewu wykonuje się także celem oceny pod kątem obecności przerzutów odległych:
- rtg klatki piersiowej
- USG jamy brzusznej
- badanie scyntygraficzne kości
Różnicowanie
W diagnostyce różnicowej guza jamy nosowo-gardłowej należy uwzględnić, zwłaszcza w sytuacji niestwierdzenia przerzutów nowotworu:
- lethal midline granuloma
- idiopathic midline destructive disease
- ziarniniakowatość z zapaleniem naczyń
- siatkowicę wielopostaciową
- chłoniaka nosogardła.
Leczenie
Charakter guza uniemożliwia uzyskanie radykalności zabiegu operacyjnego. Z tego względu leczeniem z wyboru jest radioterapia. W przypadkach zmienionych węzłów chłonnych szyi, wyleczenia radioterapią ogniska pierwotnego i nieobecności przerzutów odległych, wskazana jest radykalna operacja układu chłonnego szyi sposobem Jawdyńskiego-Crile’a. Alternatywną metodą jest selektywna radioterapia okolicy szyi.
Klasyfikacja ICD10
| kod ICD10 | nazwa choroby |
|---|---|
| ICD-10: C11 | Nowotwór złośliwy części nosowej gardła |
| ICD-10: C11.0 | Ściana górna części nosowej gardła |
| ICD-10: C11.1 | Ściana tylna części nosowej gardła |
| ICD-10: C11.2 | Ściana boczna części nosowej gardła |
| ICD-10: C11.3 | Ściana przednia części nosowej gardła |
| ICD-10: C11.8 | Zmiana przekraczająca granice jednego umiejscowienia w obrębie części nosowej gardła |
| ICD-10: C11.9 | Część nosowa gardła, umiejscowienie nieokreślone |
Przypisy
- 1 2 Gulec SA, Hoenie E, Hostetter R, Schwartzentruber D. PET probe-guided surgery: applications and clinical protocol. „World J Surg Oncol”. 5, s. 65, 2007. DOI: 10.1186/1477-7819-5-65. PMID: 17555587.
- ↑ Jackson C. Primary carcinoma of the nasopharynx: a table of cases JAMA 1901; 37: 371-377
- ↑ Regaud C. Lympho-épitheliome de l'hypopharynx traité par la roentgenthérapie. „Bull Soc Franc Otorhinolaryngol”. 34, s. 209-214, 1921.
- ↑ Schmincke A. Über lymphoepitheliale Geschwülste. „Beitr Pathol Anat”. 68, s. 161-170, 1921.
- ↑ Schmincke-Regaud tumour w bazie Who Named It (ang.)
- ↑ Digby KH Nasopharyngeal carcinoma. Br J Surg 1941; 27: 517–37.
- ↑ DIGBY KH. Nasopharyngeal carcinoma.. „Ann R Coll Surg Engl”. Oct;9. 4, s. 253-65, 1952. PMID: 14878362.
- ↑ Henle G., Henle W. Epstein-Barr virus-specific IgA serum antibodies as an outstanding feature of nasopharyngeal carcinoma.. „Int J Cancer”. Jan 15;17. 1, s. 1-7, 1976. PMID: 175020.
- ↑ Bień S, Kawecki A, Krajewski A, Starościak S Zasady diagnostyki i chirurgicznego leczenia nowotworów głowy i szyi Magazyn Otorynolaryngologiczny 2002; 1(13)
- ↑ Brennan B. Nasopharyngeal carcinoma. „Orphanet J Rare Dis”. 1, s. 23, 2006. DOI: 10.1186/1750-1172-1-23. PMID: 16800883.
- ↑ Sun LM., Li CI., Huang EY., Vaughan TL. Survival differences by race in nasopharyngeal carcinoma.. „Am J Epidemiol”. Feb 1;165. 3, s. 271-8, 2007. DOI: 10.1093/aje/kwk008. PMID: 17090616.
- ↑ Ellouz R., Cammoun M., Attia RB., Bahi J. Nasopharyngeal carcinoma in children and adolescents in Tunisia: clinical aspects and the paraneoplastic syndrome. „IARC Sci Publ”. 20, s. 115-29, 1979. PMID: 730188.
- ↑ Nielsen NH., Mikkelsen F., Hansen JP. Nasopharyngeal cancer in Greenland. The incidence in an Arctic Eskimo population.. „Acta Pathol Microbiol Scand [A]”. Nov;85. 6, s. 850-8, 1978. PMID: 203161.
- ↑ Buell P. The effect of migration on the risk of nasopharyngeal cancer among Chinese.. „Cancer Res”. May;34. 5, s. 1189-91, 1974. PMID: 4842361.
- ↑ Wolf H, zur Hausen H, Becker V. EB viral genomes in epithelial nasopharyngeal carcinoma cells. „Nat New Biol”. 244. 138, s. 245-7, 1973. PMID: 4353684.
- ↑ Neel HB, Pearson GR, Taylor WF. Antibodies to Epstein-Barr virus in patients with nasopharyngeal carcinoma and in comparison groups. „Ann Otol Rhinol Laryngol”. 93. 5 Pt 1, s. 477-82, 1984. PMID: 6093669.
- ↑ Yu MC, Ho JH, Lai SH., Henderson BE. Cantonese-style salted fish as a cause of nasopharyngeal carcinoma: report of a case-control study in Hong Kong. „Cancer Res”. 46. 2, s. 956-61, 1986. PMID: 3940655.
- ↑ Yu MC, Henderson BE. Intake of Cantonese-style salted fish as a cause of nasopharyngeal carcinoma. „IARC Sci Publ”. 84, s. 547-9, 1988. PMID: 3679441.
- ↑ Yu MC, Mo CC, Chong WX, Yeh FS, Henderson BE. Preserved foods and nasopharyngeal carcinoma: a case-control study in Guangxi, China. „Cancer Res”. 48. 7, s. 1954-9, 1988. PMID: 3349469.
- ↑ Farrow DC, Vaughan TL, Berwick M, Lynch CF, Swanson GM, Lyon JL. Diet and nasopharyngeal cancer in a low-risk population. „Int J Cancer”. 78. 6, s. 675-9, 1998. PMID: 9833758.
- ↑ He JF, Jia WH, Fan Q, Zhou XX, Qin HD, Shugart YY, Zeng YX. Genetic polymorphisms of TLR3 are associated with Nasopharyngeal carcinoma risk in Cantonese population. „BMC Cancer”. 7, s. 194, 2007. DOI: 10.1186/1471-2407-7-194. PMID: 17939877.
- ↑ Shanmugaratnam KS, Sobin LH: Histological typing of upper respiratory tract tumors. Geneva: World Health Organization; 1978. OpenURL
- ↑ Shanmugaratnam K, Sobin LH. Histological typing of tumours of the upper respiratory tract and ear. International histological classification of tumours no. 19. Geneva WHO, 1991: 32-33
- ↑ Dubrulle F., Souillard R., Hermans R. Extension patterns of nasopharyngeal carcinoma.. „Eur Radiol”. Oct;17. 10, s. 2622-30, 2007. DOI: 10.1007/s00330-007-0616-z. PMID: 17404741.
- ↑ Ozyar E., Atahan IL., Akyol FH., Gürkaynak M., Zorlu AF. Cranial nerve involvement in nasopharyngeal carcinoma: its prognostic role and response to radiotherapy.. „Radiat Med”. 12. 2, s. 65-8, 1994. PMID: 8079005.
- ↑ Wei WI, Sham JS. Nasopharyngeal carcinoma.. „Lancet”. 365. 9476, s. 2041-54, 2005. DOI: 10.1016/S0140-6736(05)66698-6. PMID: 15950718.
- ↑ Chong VF., Khoo JB., Fan YF. Imaging of the nasopharynx and skull base.. „Neuroimaging Clin N Am”. 14. 4, s. 695-719, 2004. DOI: 10.1016/j.nic.2004.07.014. PMID: 15489149.
- ↑ Sham JS., Cheung YK., Chan FL., Choy D. Nasopharyngeal carcinoma: pattern of skeletal metastases.. „Br J Radiol”. 63. 747, s. 202-5, 1990. PMID: 2334832.
- ↑ Nowotwory w otolaryngologii. Witold Szyfter (red.). Poznań: Termedia, 2012, s. 227-229. ISBN 978-83-62138-80-7.
- ↑ Ho JHC: Stage classification of nasopharyngeal carcinoma: a review.. 1978, 1978. [dostęp 2012-11-04]. (ang.).
- ↑ Rak jamy nosowo-gardłowej. W: Grzegorz Janczewski: Otorynolaryngologia praktyczna. Podręcznik dla studentów i lekarzy. Tom I. Grzegorz Janczewski (red.). Gdańsk: Via Medica, 2007, s. 361-366. ISBN 978-83-60072-75-2.
Bibliografia
- Alan G. Gibb, Alan G. Glibb: Nasopharyngeal Carcinoma. Greenwich Medical Media. ISBN 1-84110-037-4.
- Rak jamy nosowo-gardłowej. W: Grzegorz Janczewski: Otorynolaryngologia praktyczna. Podręcznik dla studentów i lekarzy. Tom I. Grzegorz Janczewski (red.). Gdańsk: Via Medica, 2007, s. 361-366. ISBN 978-83-60072-75-2.
- Brennan B. Nasopharyngeal carcinoma. „Orphanet J Rare Dis”. 1, s. 23, 2006. DOI: 10.1186/1750-1172-1-23. PMID: 16800883.
- Lin HS, Berry GJ, Sun Z, Fee WE. Cyclin D1 and p16 expression in recurrent nasopharyngeal carcinoma. „World J Surg Oncol”. 4, s. 62, 2006. DOI: 10.1186/1477-7819-4-62. PMID: 16953893.
Linki zewnętrzne
- NASOPHARYNGEAL CARCINOMA w bazie Online Mendelian Inheritance in Man (ang.)
Przeczytaj ostrzeżenie dotyczące informacji medycznych i pokrewnych zamieszczonych w Wikipedii.